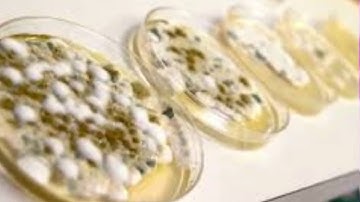
795 GermSensor Lessons Learned

⬇ DOWNLOAD NOW
Kalau muncul iklan pop-up, tutup lalu klik tombol kembali
Download lagu 795 GermSensor Technical Video NSF I-Corps secara gratis hanya untuk keperluan promosi. Dukung artis favorit kamu dengan membeli musik original di iTunes atau platform resmi lainnya.
795 GermSensor Lessons Learned
795 GermSensor Lessons Learned
 830 Biofuelent NSF ICorps Video
830 Biofuelent NSF ICorps Video
 NSF I-Corps - Team 508 QSM Diagnostics Technical Video
NSF I-Corps - Team 508 QSM Diagnostics Technical Video
 NSF I-Corps: 767 WiFi-Amber Technical Video
NSF I-Corps: 767 WiFi-Amber Technical Video
 284 CMU Technical Video - NSF I-Corps
284 CMU Technical Video - NSF I-Corps
 831 BioSense Technical Video
831 BioSense Technical Video
 VisiSonics ICorps Scientific Video
VisiSonics ICorps Scientific Video
 237 ICorps Technical Video
237 ICorps Technical Video